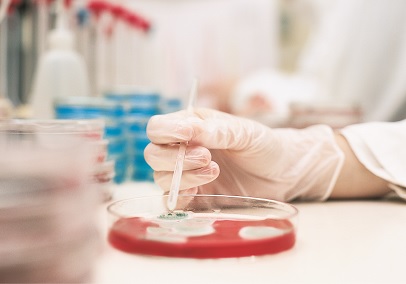
Image with missing alt attribute found on urologyhealth.org

✅ 8 criteria passed
❌ 3 criteria to solve
Boost urologyhealth.org's SEO with Kontactr's Guest Posting.
Secure high-authority, do-follow backlinks from our trusted site—DA44 domain authority and PA55 homepage and blog pages.
Perfect for webmasters seeking higher search rankings and increased organic traffic.
Simple, quick, and effective.
opens a new window
Home - Urology Care Foundation
https://urologyhealth.org
Welcome to UrologyHealth.org, your trusted resource for reliable urologic patient education. The Urology Care Foundation is educating patients and funding answers.
https://urologyhealth.org
Home - Urology Care Foundation
Welcome to UrologyHealth.org, your trusted resource for reliable urologic patient education. The Urology Care Foundation is educat...
No 301 redirects are in place to redirect traffic to your preferred domain. Pages that load successfully both with and without www. are treated as duplicate content! Not all versions of your page point to the same URL.
| Attribute | Value |
| ⓘ viewport | width=device-width, initial-scale=1.0 |
| ⓘ robots | This attribute is present but empty. |
ⓘ The results of our semantic analysis are shown below using the website's language.
They are the main concepts covered by urologyhealth.org.
Each concept has a confidence score. The higher it is, the more important the topic is relative to the page.
| Topics | |
Urology Confidence: 79% 
|
|
Health care Confidence: 66% 
|
|
Patient Confidence: 63% 
|
❌ urologyhealth.org website speed is slow. Page speed is important for visitors and search engines.
Get insights to improve your page loading time.
This domain loads at the median speed of 3.6 seconds.
urologyhealth.org is faster than approximately 17 percent of the web. Your website page speed needs to be as fast as you can make it, without compromising the customer experience.
A good goal to achieve is a loading time of 2 seconds on desktop and mobile devices.

ⓘ This website is ranked #146.864 by Alexa.
This rank is traffic based. The lower the rank is, the better the domain is ranked.
| Country | Rank |
 United States of America United States of America |
#71.906 |
 India India |
#61.035 |
 Jordan Jordan |
#5.464 |
Mobile Rendering
This website seems to be optimized for Mobile Visitors.
Phone
Tablet
A good text to HTML ratio is anywhere from 25 to 70%.
This percentage refers to the visible text ratio, as opposed to HTML elements, image tags and other non-visible information.
Great, we found headings on this page.
However, you have not defined a top level heading, or <H1>. It is used to define the most important heading.
We recommend using one top level heading to set up a semantic relationship between that heading and the remainder of the content on a page. It clearly describes to the readers and the search engines what it is about.
| 2nd level heading |
| Featured resources |
| 3rd level heading |
| Managing ınterstitial cystitis |
| What is ımmunotherapy for bladder cancer? |
| Bladder health exercises |
| Ask the experts: how do ı know if ı have a urinary tract ınfection (utı)? |
| Recent tweets |
| 4th level heading |
| Public education council |
| Planned giving |
| Free patient education materials |
| Fall uhe highlights |
| Lifestyle tips for good urologic health |
| Research |
| ıt's time to talk about oab |
| We want to hear your story |
| ıt's time to talk about suı |
| Media center |
| Make a difference |
| Quick links |
| 5th level heading |
| Urology care foundation |
We found 20 images on this website.
20
ALT attributes are missing on your image tags.
Alternative text allows you to add a description to an image.
Google rely on alternative text attributes to determine relevance to a search query. Alternative text also makes an image more likely to appear in a Google image search.
It looks like you're missing alternative text for 20 images on urologyhealth.org. Check your website to make sure it's specified for each image on the page.
For a better readability, only the first 50 internal links are shown below.
| Anchor | Type | URL |
| No anchor | empty | https://www.facebook.com/urologycarefoundation |
| No anchor | empty | http://www.twitter.com/urologycarefdn |
| No anchor | empty | https://www.youtube.com/channel/uchcz1sbvtyhpm1qmkfiojjq |
| No anchor | empty | https://www.instagram.com/urologycarefdn/ |
| No anchor | empty | https://www.pinterest.com/urologycarefoun/ |
| Donate | text | https://ebiz.urologyhealth.org/about-us/donate-now |
| ...more | text | http://urologyhealth.plannedgiving.org/ |
| ...more | text | https://urologyhealth.h5mag.com/fall19/cover |
.jpg) |
image | https://urologyhealth.h5mag.com/fall19/cover |
| Tweets by @UrologyCareFdn | text | https://twitter.com/urologycarefdn |
| image | https://www.guidestar.org/profile/20-3210212 | |
| Planned Giving | text | http://urologyhealth.plannedgiving.org/ |
| American Urological Association | text | http://www.auanet.org/ |
| ⓘ Domain Registrar | NETWORK SOLUTIONS, LLC |
| ⓘ Registration Date | 07/02/2002 23 years, 11 months, 15 days ago |
| ⓘ Last Modified | 07/01/2019 6 years, 11 months, 16 days ago |
| Host | IP Address | Country |
| ns1.auanet.org | 107.0.246.124 |  United States United States |
| ns4.auanet.org | 208.118.165.61 |  United States United States |

| Domain |



SOCIAL MEDIA PRESENCE
You're doing quiet good on social media!
Social shares are a key signal, among many others, that search engines use to evaluate the rankings of a website. Asking people to share your pages, adding visible social share buttons and make great quality content are 3 of the most powerful ways to grow your social presence.